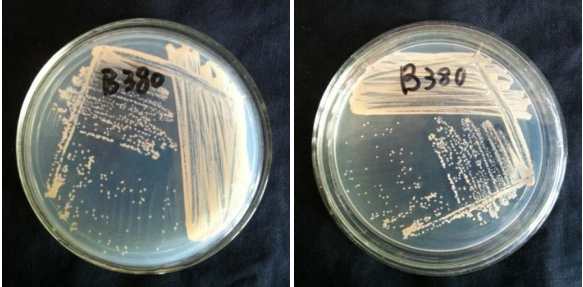

Loading...
| StrainNO | B380 |
| Classification | Ochrobactrum |
| 16s rDNA sequence | TTGCATGCGGCAGCTTACCATGCAGTCGAGCGCCCCGCAAGGGGAGCGGCAGACGGGTGAGTAACGCGTGGGAATCTACCTTTTG CTACGGAATAACTCAGGGAAACTTGTGCTAATACCGTATGTGCCCTTCGGGGGAAAGATTTATCGGCAAAGGATGAGCCCGCGTT GGATTAGCTAGTTGGTGAGGTAAAGGCTCACCAAGGCGACGATCCATAGCTGGTCTGAGAGGATGATCAGCCACACTGGGACTGA GACACGGCCCAGACTCCTACGGGAGGCAGCAGTGGGGAATATTGGACAATGGGCGCAAGCCTGATCCAGCCATGCCGCGTGAGTG ATGAAGGTCTTAGGATTGTAAAGCTCTTTCACCGGTGAAGATAATGACGGTAACCGGAGAAGAAGCCCCGGCTAACTTCGTGCCA GCAGCCGCGGTAATACGAAGGGGGCTAGCGTTGTTCGGATTTACTGGGCGTAAAGCGCACGTAGGCGGACTTTTAAGTCAGGGGT GAAATCCCGGGGCTCAACCCCGGAACTGCCTTTGATACTGGAAGTCTTGAGTATGGTAGAGGTGAGTGGAATTCCGAGTGTAGAG GTGAAATTCGTAGATATTCGGAGGAACACCAGTGGCGAAGGCGGCTCACTGGACCATTACTGACGCTGAGGTGCGAAAGCGTGGG GAGCAAACAGGATTAGATACCCTGGTAGTCCACGCCGTAAACGATGAATGTTAGCCGTCGGGGAGTTTACTCTTCGGTGGCGCAG CTAACGCATTAAACATTCCGCCTGGGGAGTACGGTCGCAAGATTAAAACTCAAAGGAATTGACGGGGGCCCGCACAAGCGGTGGA GCATGTGGTTTAATTCGAAGCAACGCGCAGAACCTTACCAGCCCTTGACATACCGGTCGCGGACACAGAGATGTGTCTTTCAGTT CGGCTGGACCGGATACAGGTGCTGCATGGCTGTCGTCAGCTCGTGTCGTGAGATGTTGGGTTAAGTCCCGCAACGAGCGCAACCC TCGCCTTTAGTTGCCATCATTTAGTTGGGCACTCTAAAGGGACTGCCAGTGATAAGCTGGAGGAAGGTGGGGATGACGTCAAGTC CTCATGGCCCTTACGGGCTGGGCTACACACGTGCTACAATGGTGGTGACAGTGGGCAGCAAGCACGCGAGTGTGAGCTAATCTCC AAAAGCCATCTCAGTTCGGATTGCACTCTGCAACTCGAGTGCATGAAGTTGGAATCGCTAGTAATCGCGGATCAGCATGCCGCGG TGAATACGTTCCCGGGCCTTGTACACACCGCCCGTCACACCATGGGAGTTGGTTCTGCCCGAAGGCACTGTGCTAACCGTAAGGA GGCAGGGACCACGTAGTTACGCC |
| Strain Morphology Photos | |
| Morphological Description | Colony milky white;wetnessslippy;Spherical shape of the bacterium;no spore |